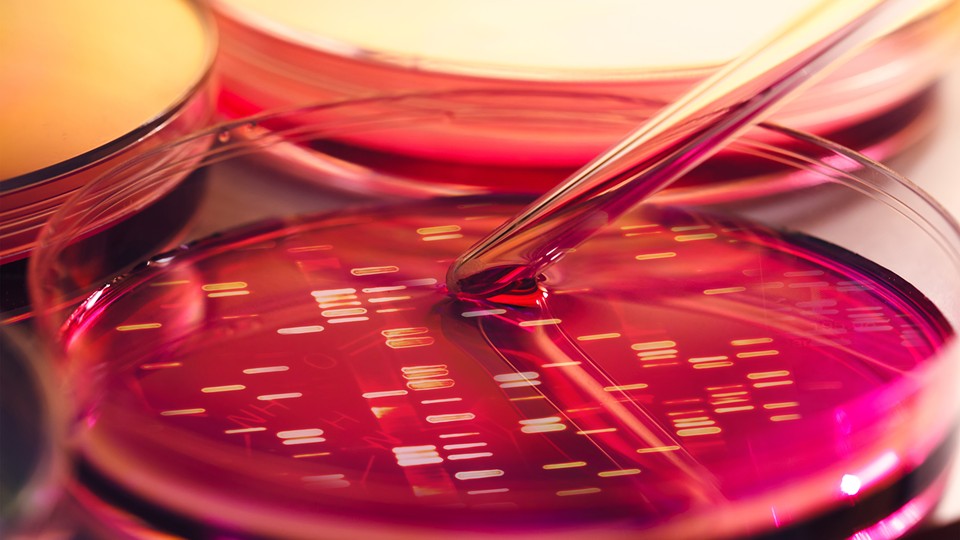

The Search for Genes That Prevent Disease
What can we learn from people with genetic predispositions to a disease who never end up getting sick?
The X-Men’s mutations gave them superpowers. Telepathy. Flight. Teleportation. Some scientists believe that there may be some among us who have a superpower in our genes, too—the ability, against all odds, to stay healthy. Finding these people is the goal behind a massive study launched by non-profit research organization Sage Bionetworks at the Fred Hutchinson Cancer Research Institute in Seattle and the Icahn Institute for Genomics and Multiscale Biology, at Mount Sinai in New York City.
Known as the Resilience Project, the study's proof-of-concept findings are published today in Science. The full project will analyze DNA from healthy volunteers to identify people with genetic mutations that are known to cause rare and severe inherited childhood diseases but who nevertheless have remained healthy. In other words, said Sage founder and president Stephen Friend, who announced the study during his TED Talk. “We’re looking at people who should have gotten sick but didn’t.”
The project relies on a whopping 1 million volunteers to donate a DNA sample from a simple cheek swab. Each anonymous sample will be scanned for 685 gene mutations that cause 127 diseases—from cystic fibrosis to sudden infant death syndrome (SIDS)—that typically manifest before the age of 18. Identifying and studying these people, who Friend has dubbed “unexpected heroes,” could provide clues to how they avoided getting ill.
“Perhaps they are carrying special mutations—helpful, not harmful ones—that are protecting them from the diseases that medical textbooks would say they are almost guaranteed to get,” Friend says. These insights, in turn, could pave the way for the development of new drugs that mimic the effect of the protective mutation to prevent a disease or lessen its severity in those who are at high risk of developing it.
“It’s really an untapped research opportunity,” says Dr. Tom Insel, director of the National Institute of Mental Health. Most genetic studies, he notes, focus on mutations that increase disease susceptibility, not on genetic or environmental factors that buffer the effects of those mutations to keep people healthy.
“Knowing how some people dodge the slings and arrows of disease that they were at extremely high risk of getting, whether through bad luck or pedigree, I suspect will tell us more about treating disease than studying those who already have it,” Insel said.
Dr. Eric Schadt, director of the Icahn Institute, professor of genomic science at Mount Sinai’s School of Medicine and co-principal Investigator of the Resilience Project, says evidence of such buffering exists across species, including humans, and is well-documented throughout the medical literature universe. Rare mutations in one gene block HIV infection, for example, while mutations in another dramatically lower cholesterol levels and make a person virtually immune to heart disease.
There are others, too. Schadt points to two patients who have come through Mt. Sinai: a woman in her mid-50’s with a mutation in the CFTR gene—the gene understood to cause 100 percent of all cases of cystic fibrosis—who has never had more than mild respiratory issues. And a 45-year-old man who learned during an unrelated medical procedure, that he had Louis–Bar syndrome—a rare neurological disorder caused by a gene mutation—though he had never exhibited any symptoms of the usually fatal disease.
“Both carry the code for an inherited childhood disease but do not bear the symptoms of the disease,” he said. “This Resilience Project hopes to uncover others like them who, everyday, unbeknownst to them, are walking around, buffering against illnesses they were all but guaranteed to get.”
He estimates that one person in about every 25,000 people has a gene that places them at exceptionally high risk for a disease they were somehow able to avoid, but to date there have not been large-scale, systematic efforts to profile large numbers of individuals to identify those who were successfully protected.
Until recently, he says, profiling more than two to three genes per patient posed considerable challenges in both time and cost. But recent technological advances, which have dramatically slashed the time and cost of gene sequencing technologies, and the arrival of supercomputers, which make sense of mega-datasets at dizzying speed, have made it possible to screen each DNA sample for “tens of dollars” in a “matter of hours.”
“Of course, any potential unexpected hero candidates would takes days more of validation—both computationally and biologically,” he said. “But the numbers will be small enough to handle that.”
Still, the loftiness of such a project—it’s the largest study to have been conducted, ever—is lost on neither Friend nor Schadt. To make sure a study of this magnitude was even possible, they retrospectively analyzed data from more than 590,000 previously collected DNA-samples, from which several potential heroes candidates have already emerged. With the Resilience Project’s proof-of-concept having been established and early findings published today in Science, Friend expects the main challenge is recruiting the army of volunteers required to find even just a handful of unexpected heroes. It is also working with partners worldwide to reach volunteers from different populations, in different environmental settings, with different histories.
“It is critical that a wide range of individuals participate for this novel approach to succeed,” said Sharon Terry, president and CEO of Genetic Alliance, a non-profit health advocacy group. As an outreach partner in the Resilience Project, Genetic Alliance will tap into its network of more than 1,200 patient advocacy organizations, as well as thousands of universities, private companies, government agencies, and public policy organizations, to recruit potential volunteers. “There is power in numbers. The more people who step up, the greater the chance that discoveries will be made that change the way we prevent and treat serious medical disorders,” Terry added.
Anyone older than 40—by which time a disease known to emerge in childhood should have manifested—can also enroll themselves via the study’s website, and a resilience test kit will be sent to them by mail. The kit includes instructions for collecting a DNA sample using a sterile bristle brush provided in the kit and returning the sample by mail.
Once the project’s research team has completed the analysis of a volunteer’s DNA sample, he or she will receive a report indicating whether genetic mutations that typically cause rare diseases were detected. “If you are identified as a resilient candidate, a research scientist will contact you to discuss potential next steps, if you are interested,” said Friend.
Eventually, Friend says the hope is to extend the Resilience Project beyond inherited childhood disease to wide spectrum of more common adult diseases—such as Alzheimers, cancer, and Parkinson’s disease—that can affect us throughout our lives.